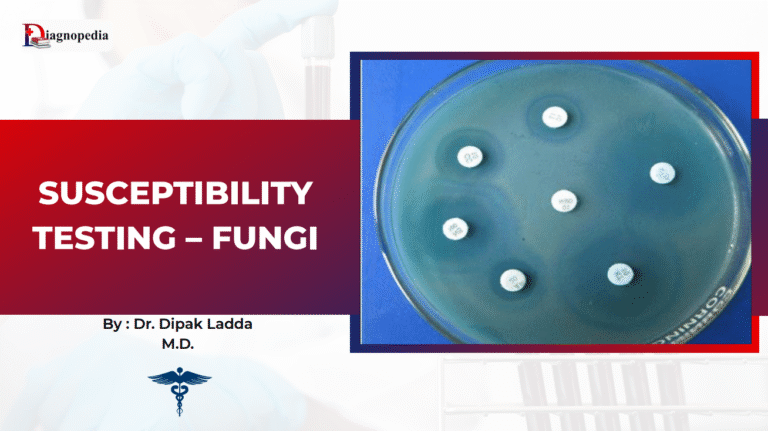
Antifungal Susceptibility Testing (AFST)

Library
Explore curated doctoral theses and clinical presentations— organized for clarity, built for quick reference, and trusted by the medical community.
Start Exploring 850+ Medical Topics
Ex: Cholesterol
Featured Topics
Overview Antifungal Susceptibility Testing (AFST) is an essential diagnostic tool in clinical microbiology laboratories. Its primary aim is to determine...

Overview Anti-ssDNA antibody refers to immunoglobulin G (IgG) antibodies directed against single-stranded DNA (ssDNA). As outlined in the document, this...

Overview The Anti-SS-B (La) antibody is an autoantibody produced by the immune system that targets the SS-B/La antigen, a ribonucleoprotein...

Overview Anti-SS-A Antibody, also known as Anti-Ro antibody, is an autoantibody produced by the immune system against the SSA (Ro)...

Overview Anti-Sm Antibody is an autoantibody directed against small nuclear ribonucleoproteins (snRNPs), specifically the Smith (Sm) antigen, which is located...












